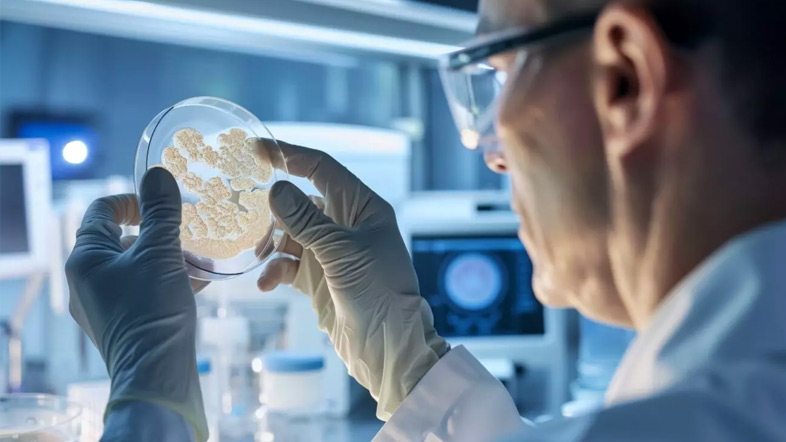
Рак остановят на нулевой стадии

Лучшие врачи израиля
МИССИЯ
Забота о здоровье и высоком качестве жизни пациентов клиники, посредством предоставления профессионального медицинского обслуживания и с уважением к человеческой жизни и достоинству. Мы высоко ценим свободу выбора каждого нашего пациента и его семьи, при этом мы стремимся гарантировать нашим пациентам максимальный положительный результат.
Мы обязуемся являть собой образец достойного применения выдающихся достижений в сфере медицины Израиля. Каждый день мы стремимся оправдать оказанное нам доверие предоставляя пациентам медицинские услуги высочайшего качества.

Подтверждение высокого качества медицинских услуг раз в 3 года международной экспертной комиссией. Оценка более 1500 показателей.
ЦЕННОСТИ
- Здоровье
Мы предоставляем пациентам наилучшее медицинское обслуживание, без каких-либо оговорок и компромиссов. - Прозрачность
Мы гарантируем максимально возможную прозрачность и честность перед нашими пациентами. - Важность пациента
Медицинские проблемы каждого пациента воспринимаются нами с максимальной серьезностью. - Доступность
Мы постоянно находимся на связи с пациентами, в том числе в праздничные и выходные дни, а также в любое время суток. - Участие и неравнодушие
Мы с заботой и участием относимся к каждому пациенту независимо от его расы, пола и вероисповедания.
Фото пациентов
Все фотографииВидеоотзывы
ВСЕ ОТЗЫВЫКАК ПРИЕХАТЬ К НАМ НА ЛЕЧЕНИЕ






Новости
Официальный сайт клиники Ассута
Клиника «Ассута» – единственный медицинский центр в Израиле, где работают только опытные профессионалы, доказавшие свою компетентность и подтвердившие знания реальными результатами в лечении. Тщательно продуманное здание клиники «Ассуты» имеет 10 этажей, 16 операционных, более 200 больничных коек, 12 палат интенсивной терапии, 2 лаборатории. Ассута – одна из крупнейших клиник Израиля в онкологии. В хирургическом центре проводится более 500 различных видов операций, при этом % инфекционных послеоперационных осложнений самый низкий среди клиник Израиля.
В Израиле клиника «Ассута» – это центр обучения и повышения квалификации профессионалов в медицинской сфере со всего мира. Тут также проводятся многочисленные клинические исследования, в том числе новейшего диагностического аппарата PET-MRI, химиопрепаратов для лечения некоторых видов рака и препаратов, поддерживающих иммунитет онкобольных.
Тысячи иностранных туристов приезжают в Израиль, клинику «Ассута», на лечение рака, эпилепсии, сахарного диабета, а также чтобы провести пересадку костного мозга, операции на сердце, ЭКО, радиологические процедуры и многое другое.